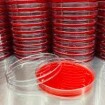

Thông tin tổng quan
- http://mdlasia.vn/thong-tin-...
- Hồ Chí Minh
- 0934880049
- 100 - 200 nhân viên
- Bán hàng/ Kinh doanh
- Từ 50 - 100 tỷ đồng
- Công ty cổ phần ngoài NN
- 2018
CÔNG TY CỔ PHẦN MDL ASIA
MDL ASIA là doanh nghiệp đầu tư cho dây chuyền sản xuất quy mô lớn. Với hệ thống trang thiết bị hiện đại cùng đội ngũ nhân viên trình độ cao, nhiều năm kinh nghiệm trong lĩnh vực sản xuất trang thiết vị y tế và phát triển phòng xét nghiệm.
Sử dụng các nguyên liệu tốt nhất sử dụng từ các đối tác nước ngoài ( Merck, BD, Duran...) và nhà sản xuất lớn trong nước.
Chính sách bảo hiểm
- Được hưởng các chế độ bảo hiểm : BHYT, BHXH, BHTN
- Hưởng quyền lợi bảo hiểm 24/7
Các hoạt động ngoại khóa
- Du lịch hàng năm
- Team building theo quý
- Các hoạt động vui chơi, giải trí, ca hát thường xuyên
- Thể thao: Đá bóng, bóng chuyền,..
Lịch sử thành lập
- Công ty được thành lập năm 2018
Mission
Với hệ thống quản lý chất lượng ISO 9001:2015 và ISO 13485:2016, sản phẩm chúng tôi sản xuất đều đảm bảo các yêu cầu nghiêm nghặt về chất lượng và có sự đồng bộ trước khi đưa ra thị trường